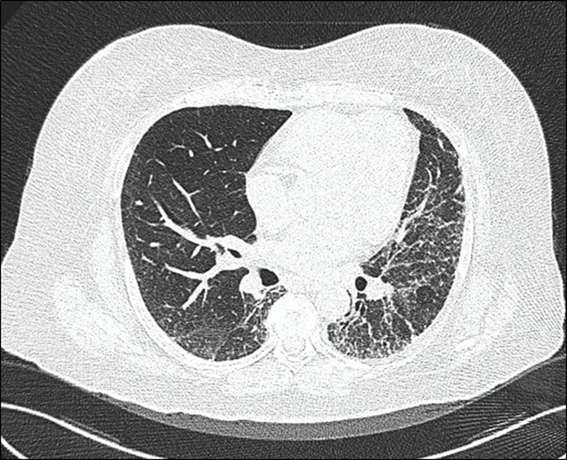

INTRODUCCIÓN
En reumatología, existen pocas entidades con la condición sine (locución latina que significa “sin”); son enfermedades raras en las que está ausente la característica más florida que define a la entidad; por ejemplo, ausencia de debilidad en polimiositis o de esclerosis cutánea en la esclerosis sistémica progresiva (ESP). La ESP es una enfermedad, en la que la fibrosis idiopática es la regla. Su sello distintivo es la esclerosis cutánea, cuya presencia facilita en gran medida su diagnóstico rápido y certero. Se clasifica en cutánea limitada (EScl), cutánea difusa (EScd), preesclerodermia y esclerosis sistémica sine esclerodermia (ESse)1.
La ESse es una entidad poco frecuente de ESP en su variedad limitada (2-10% de casos) y está reconocida como variante de la ESP, su diagnóstico está determinado por fenómeno de Raynaud (FRy), compromiso visceral y anticuerpos específicos presentes: Anticuerpos anticentromérico (AAC) o anticuerpos antitopoisomerasa (AAT), también llamados Anti-Scl 70. Al ser la ESse una entidad poco común, se suele tardar el diagnóstico, problema que conlleva a una progresión de las complicaciones (avance inexorable del compromiso pulmonar y digestivo). Por ende, ante un paciente con fenómeno de Raynaud, afectación pulmonar (fibrosis y/o hipertensión pulmonar) y afectación del tubo digestivo (gastroparesia, reflujo gastroesofágico, constipación, disfagia, pirosis, etcétera) se deberá investigar AAC o AAT para establecer el diagnóstico de ESse2.
Si bien es cierto, en la ESse, no hay compromiso cutáneo, esto no difiere en las demás características clínicas o laboratoriales que pueden existir, por lo que el pronóstico es tan igual como en una ESP con compromiso cutáneo. El tratamiento de una ESse tampoco difiere en la forma clásica de ESP, pero la regla es que casi todos los pacientes con ESse inician el tratamiento de manera tardía, cuando la fibrosis visceral (pulmonar, digestiva, renal) ya generó daño irreversible, debido a la rareza de esta entidad3.
El objetivo y justificación del presente reporte es relacionar un ANA elevado con patrón centromérico asociado a afectación pulmonar y digestiva con una rápida sospecha diagnóstica de esclerodermiasineesclerodermia, entidad francamente rara.
PRESENTACIÓN DEL CASO
Mujer de 63 años, casada, ama de casa, procedente de la amazonía peruana. No presenta antecedentes patológicos. Niega tabaquismo y alcoholismo. Inició tos seca esporádica, sin fiebre ni pérdida de peso. La tos persistió y se cronifica en el tiempo. A los ocho meses de iniciado el cuadro, apareció cansancio progresivo y fatiga, por lo que acude a hospital donde el examen físico del aparato respiratorio reveló crepitantes difusos tipo velcro en 2/3 inferiores de ambos campos pulmonares. La radiografía al tórax comprobó fibrosis pulmonar, en patrón de vidrio deslustrado (figura 1).

Figura 1. Radiografía de tórax donde se aprecia patrón difuso de vidrio deslustrado en 2/3 inferiores de inferiores de ambos campos pulmonares
Además, paciente inicia disconfort postprandial, con sensación de llenura y disfagia. No hay variación en el apetito. La paciente es referida a un hospital nacional en Lima y se inicia estudio de la causa de la fibrosis pulmonar y dispepsia. En los exámenes auxiliares, en los resultados se ve dentro de la normalidad, excepto títulos elevados de Anticuerpos Antinucleares (ANA) en 1/5120 con patrón centromérico. Con dicho resultado se inició estudio de enfermedad autoinmune. El examen físico de abdomen no fue contributorio. Se realizó Tomografía Axial Computarizada (TAC) torácica (figura 2) donde se informa engrosamiento intersticial de tipo reticular a predominio subpleural posterobasal tipo panal de abeja en 2/3 inferiores pulmonares. Se realiza test de caminata, sin alteraciones.
Durante la estancia hospitalaria, se verifica en reiteradas veces fenómeno de Raynaud, y no se evidencian otras lesiones cutáneas. Las manos de la paciente tampoco mostraron lesiones distinguibles o características (figura 3). Se realizó radiografía contrastada del tubo digestivo (figura 4) y se demostró retardo en el vaciamiento en niveles superiores (esófago y estómago), pero no se visualizó dilataciones. Se sometió a capilaroscopía digital, en la que se evidencia hemorragias en astilla en el 3.erdedo de mano izquierda.
Figura 2. Se pone en evidencia panalización progresiva a predominio subpleural, motivo del cansancio y fatiga en la paciente
Ante la tríada existente (fibrosis pulmonar, afectación digestiva y fenómeno de Raynaud) se hace el diagnóstico probable de una entidadsine. Se solicita estudio de anticuerpos para esclerosis sistémica (anticuerpos anticentromérico -AAC- y antitopoisomerasa -AAT-). El resultado arrojó niveles elevados de AAT. Se concluye en una Esclerosis Sistémicasineesclerodermia (ESse). Se inicia tratamiento con azatioprina 100 mg diarios, manejo que causa intolerancia digestiva, y se cambió a ácido micofenólico (MMF) 2 gramos diarios; además, se indica procinéticos para afectación digestiva.

Figura 3. Además del fenómeno de Raynaud, no se evidenció afectación cutánea proximal ni distal en ambas manos
La paciente inicia mejoría progresiva de cuadro pulmonar y digestivo. Actualmente, está con mejoría progresiva presente. Mantiene MMF 1 gramo diario y ganancia ponderal de peso.
DISCUSIÓN
A diferencia de las referencias bibliográficas revisadas (donde se clasifica a la ESse como una variante de EScl y positividad necesaria para AAC), nuestra paciente tuvo ES sine esclerodermia, pero como una variante de la forma cutáneo difusa, pues presentó positividad para AAT y enfermedad intersticial pulmonar asociada4.
Se han propuesto tres tipos de ESse: tipo 1 (ausencia total de afectación cutánea), tipo 2 (ausencia de esclerosis cutánea, pero presencia de telangiectasias, calcificaciones o cicatrices) y tipo 3 (aparición tardía de afectación cutánea posterior a la afectación visceral)5.
La paciente inició la enfermedad con un cuadro respiratorio; por tanto, es de tipo 1. Teniendo en cuenta que hubo una demora de aproximadamente dos años en el diagnóstico definitivo de ESse en la paciente; dicha espera concuerda con el tiempo promedio (2.5 + 1.5 años)6.
El inmunosupresor de elección en una ESP es metotrexato (MTX), siendo opciones válidas azatioprina y micofenolato. Esto cambia en la ESse, pues al no haber afectación cutánea y compromiso pulmonar (como fue el caso de nuestra paciente) los fármacos de elección son AZA o MMF. Ante un paciente con ESse y afectación general o compromiso vital, se prefiere ciclofosfamida. Los corticoides están casi proscritos en todas las variedades de ESP (incluye a su formasine)7.
El pronóstico de los pacientes con ESse es bueno (similar a la forma cutáneo limitada), sin embargo, esto depende en gran medida del tiempo de demora del diagnóstico y del órgano afectado8.
La paciente tiene enfermedad intersticial pulmonar y digestiva, pero la buena respuesta a MMF la favorece y se considera que tiene buen pronóstico. La EScl también tiene otra variedad poco frecuente llamado síndrome CREST, en donde la afectación cutánea se da en forma de calcinosis característica9.